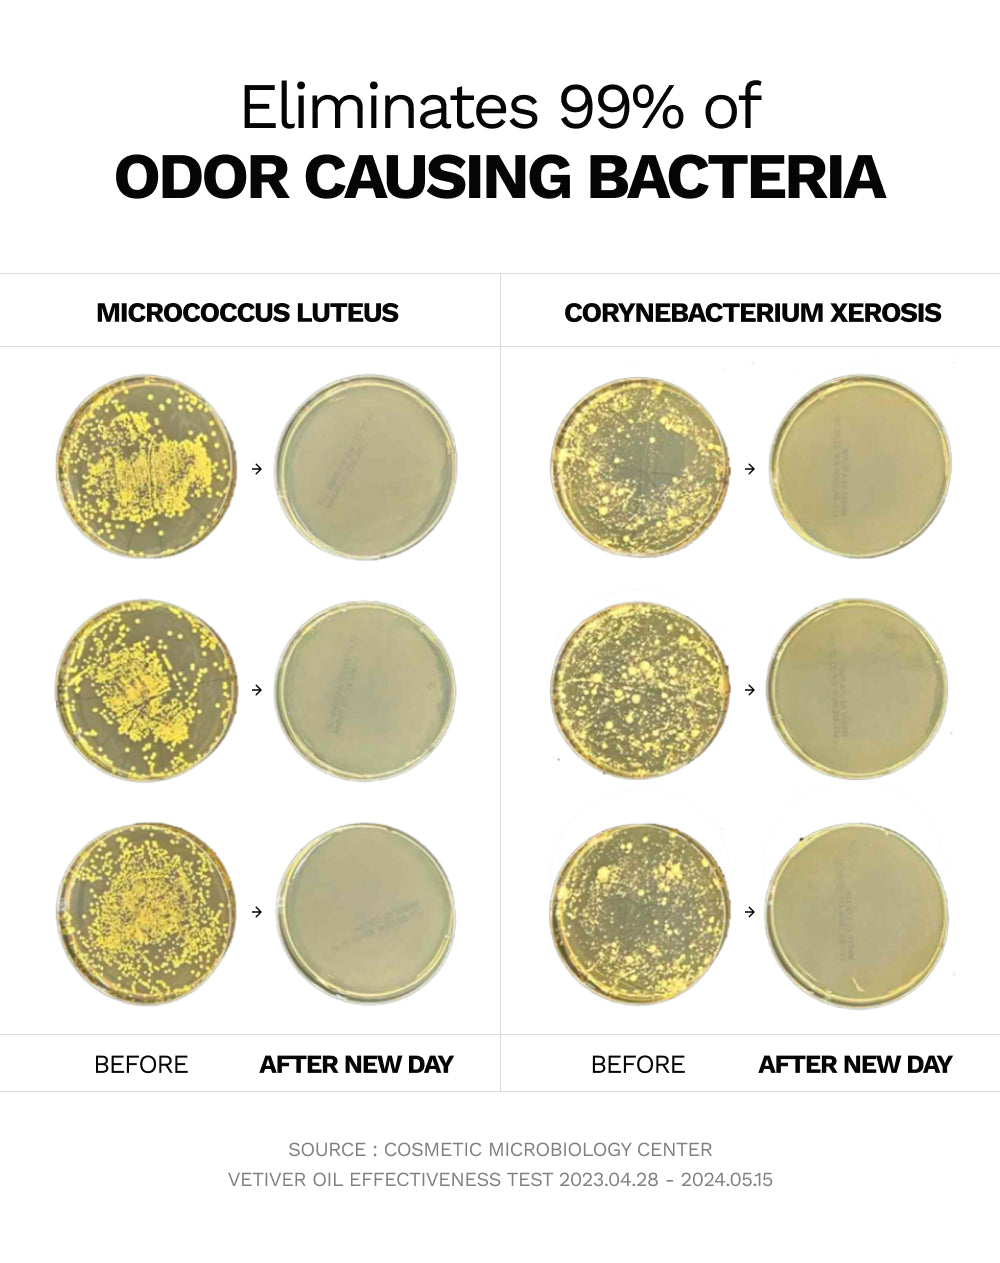

NEW DAY | HERBAL DEODORANT
Eliminates 99% of odor-causing bacteria for all-day protection.
- Smoothes and protects delicate underarm skin
- Helps reduce the appearance of underarm hyperpigmentation
- Infused with bergamot oil and free of aluminum, parabens, and phthalates
- Features an herbal roll-on design for easy daily use
$29.00

Unavailable
KEY INGREDIENTS
- Vetiver Oil - Removes 99.9% of odor-causing bacteria
- Korean Seaweed Extract - Protects and soothes the skin
- Vitamin C - Helps minimize the look of discoloration and ingrowns.
- Bergamot Oil - Helps you start your day with positivity.
Ingredients: Water, Alcohol, C12-14 Alketh-12, Propanediol, 1,2-Hexanediol, Hydroxypropyl Methylcellulose, Fragrance, Benzyl Benzoate, Butylene Glycol, Alpha-Isomethyl Ionone, Linalool, Limonene, Ethylhexylglycerin, Undaria Pinnatifida Extract, Sodium Chloride, Eugenol, Citral, Dextrin, Geraniol, Theobroma Cacao (Cocoa) Extract, Coptis Japonica Root Extract, Fucoidan, Ascorbic Acid, Citrus Aurantium Bergamia (Bergamot) Fruit Oil
FRAGRANCE NOTES
An energizing burst of citrus and soft florals that evolves into a comforting embrace of woods and vetiver.
Core Notes: Bergamot, White Rose, Vetiver.
HOW TO USE
Shake before use. Apply daily to clean, dry underarms.
RETURNS
We accept returns and exchanges within 14 days of receiving your order. To initiate a return, please reach out to us at info@houseofbalance.us. Our team is available seven days a week, and we strive to respond within 24 hours.